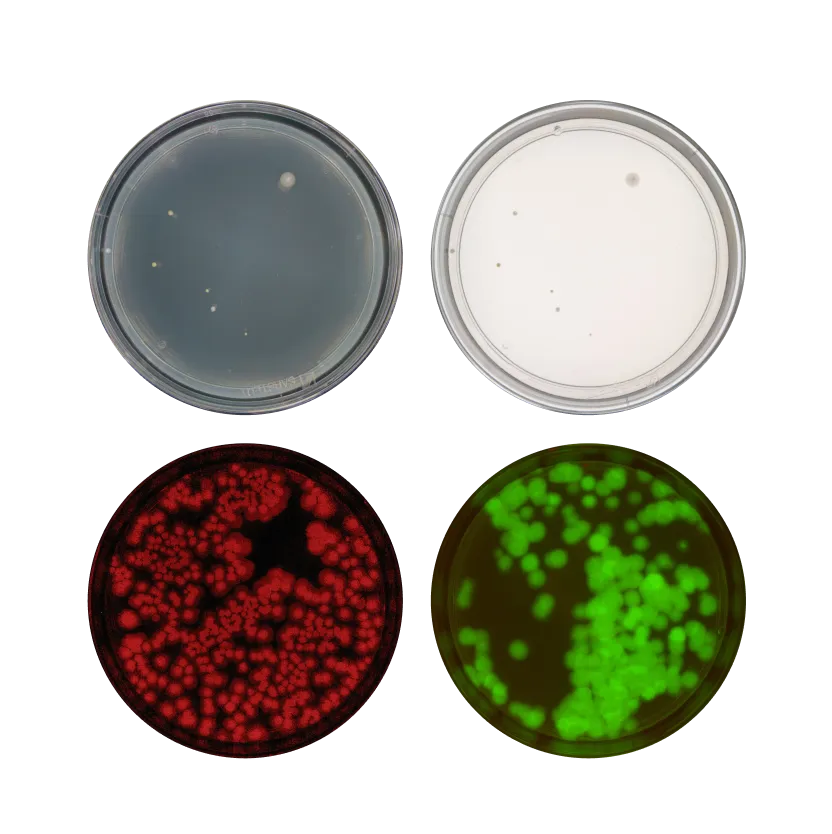

High-throughput platform for QC teams
Reshape is here to help you scale quality control without scaling headcount. Our platform helps you reduce variability and human error so your lab delivers consistent results at scale – and faster than ever – so you can keep up with demand.


Save your team from tedious manual tasks. Screen up to 200 plates per hour, and start seeing results immediately.
Analyze 400 plates at once
Load up the device and hit go. Analysis is fully automated, consistent, and independent of training or interpretation.


Captured in optimal conditions
Lids are removed from plates, which are imaged with top, bottom, and fluorescence lighting to ensure clear, accurate analysis results.
End-to-end traceability
From scanned barcode to result, everything is tracked, analyzed, and automatically logged—no manual input or missing records.

Sorted, stored, and searchable
Each result is physically and digitally sorted—so you can easily find, review, and compare data when it counts.

Built on the industry’s largest dataset
Our AI is trained on more than 40 million images—giving you accurate, out-of-the-box analysis that meets your quality standards from day one.
Smart from the start

Work with the AI, not around it

Reshape combines powerful features with approachable design, making high-end lab tools that fit right into your existing workflows.

Smart from the start
Go global – without losing control

No experts required
Once connected to the internet, you’re ready to go—no specialized operators or lengthy training courses needed.
Consistency, consistently
Standardize imaging and analysis to remove variables and deliver reliable results across all labs, every time.
Remote control
With data stored in the cloud, senior staff can monitor experiments across time zones, review results, and stay in the loop from anywhere.
Methods
We support all plate-based methods. Here's a selection of the most common ones.
















